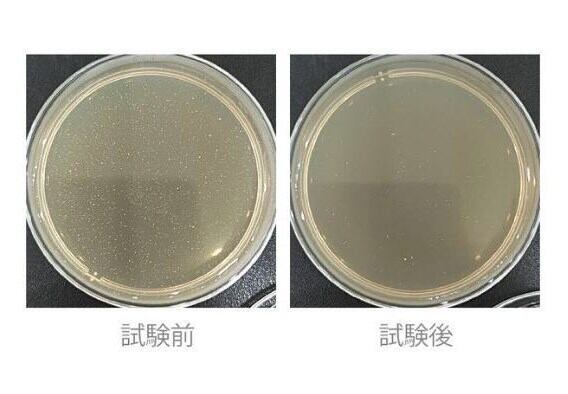

iPhone 抗菌スマホケース オーダーメイド
¥2,700 税込
なら 手数料無料で 月々¥900から
別途送料がかかります。送料を確認する
※こちらはオーダーメイド商品です。
お子様の作品や手足の型、ペットの写真、チームのロゴetc… 世界に一つだけの、素敵なオリジナルグッズにしませんか?
画像をそのまま使用することはもちろん、画像をもとにデザインやアレンジを加えて、 より可愛く、よりカッコ良く、より素敵に変身させることもできます。
ご希望のイメージをお伝えください。
商品ご購入後、ご使用になりたい画像データを [email protected] まで、送付してください。
その際、下記をご一緒にお伝えください。
・画像そのままを使用する or 一部分を切り取って使用する
・デザインを加える or デザインを加えない
・文字を追加する or 文字を追加しない
・その他ご要望
内容を確認の上、仕上がりイメージ画像などをメールにてご連絡差し上げます。
※商品画像に関しては出来る限り忠実に表示出来るよう努めておりますが、撮影時の照明や影、お客様がご利用のモニターの設定及び特性により、実際の商品と比較し色味に誤差が生じる場合があります。
※完全受注生産となっております。デザイン案完成・ご承諾後のキャンセルはお受け致しませんので、予めご了承ください。
※簡易包装での発送になります。ご了承ください。
【ご注意ください!】
ご使用いただける画像データは、オリジナルで作成された物であることを基本とし、第三者の権利(著作権や版権、商標権・肖像権・意匠権・パブリシティ権等)を侵害していない旨を、権利保有者より書面(メールや規約含む)にて許可を受けているものに限ります。
【商品詳細】
抗菌スマホケースには、除菌・抗菌効果がある銀イオン(Ag+)がケースのTPU素材と
混ぜ合わされて成型されていますので、抗菌効果は半永久的に持続します。
スマホに「トイレ便座の10倍の細菌が付着」というアメリカの大学の調査結果もあるように、
手が綺麗でもスマホに菌が付着していたら心配。ME-Qの抗菌スマホケースならトイレで
付着しやすい大腸菌や黄色ブドウ球菌からあなたを守ります。(試験結果実証済)
抗菌スマホケースは、試験結果でブドウ球菌の中で最も危険とされる黄色ブドウ球菌や大腸菌から
守るスマホケースとして実証済みです。抗菌率は99%以上と高い数値の試験結果が出ています。
抗菌スマホケースは柔らかい素材で作られております。柔らかく手触りが良い素材のTPU製スマホケースです。
ソフトタイプのケースなので取り外しも簡単。使い勝手の良い抗菌スマホケースです。
カバー装着後も充電・ボタン操作などスマホ機能はそのまま。
またTPU製の抗菌スマホケースは耐久性に優れており、落下時、ケースが衝撃を吸収します。
またカバーをする事によりスマホ本体をキズや汚れからも守ります。
銀イオンの殺菌効果(アリゾナ大学レポート)
アリゾナ大学において、銀イオンの殺菌効果を評価テストした結果、
ほとんどの病原菌に対して殺菌効果があることが証明。効果の認められた細菌は、
ブドウ球菌・サルモネラ菌・赤痢菌・クレブシェラ・レジオネラ屬菌・
シュードモナス・ポリオウィルス・ロタウィルス・ヘルペスウィルスとされております。
参照:日本イオン株式会社
【素材】
TPU製ソフトカバー
※銀イオン(Ag+)を使用
【カラー】
クリア
【印刷方法】
UVインクジェット印刷(CMYK出力)
【発送日】
デザイン完了後3営業日後
-
レビュー
(7)
-
送料・配送方法について
-
お支払い方法について
¥2,700 税込